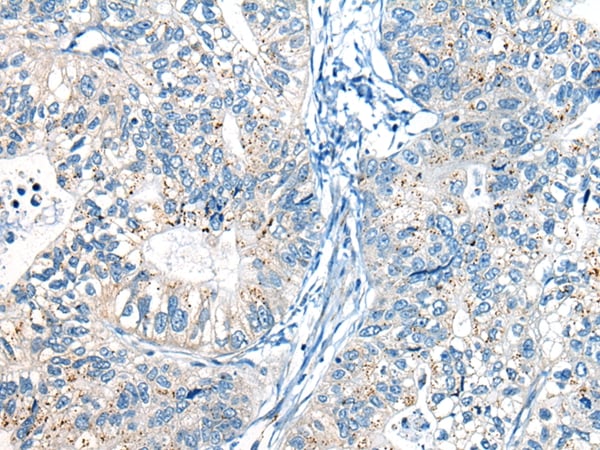
product-image-AAA310365_IHC13.jpg

Rab proteins geranylgeranyltransferase component A 1 Recombinant Protein | CHM recombinant protein
Recombinant Human Rab proteins geranylgeranyltransferase component A 1
Gene Names
CHM; TCD; GGTA; REP-1; DXS540; HSD-32
Purity
Greater or equal to 85% purity as determined by SDS-PAGE.
Synonyms
Rab proteins geranylgeranyltransferase component A 1; N/A; Recombinant Human Rab proteins geranylgeranyltransferase component A 1; Choroideremia protein; Rab escort protein 1; REP-1; TCD protein; CHM recombinant protein
Host
E Coli or Yeast or Baculovirus or Mammalian Cell
Purity/Purification
Greater or equal to 85% purity as determined by SDS-PAGE.
Form/Format
Lyophilized or liquid (Format to be determined during the manufacturing process)
Sequence Positions
1-653aa; Full Length Protein of Isoform 1
Sequence
MADTLPSEFDVIVIGTGLPESIIAAACSRSGRRVLHVDSRSYYGGNWASFSFSGLLSWLKEYQENSDIVSDSPVWQDQILENEEAIALSRKDKTIQHVEVFCYASQDLHEDVEEAGALQKNHALVTSANSTEAADSAFLPTEDESLSTMSCEMLTEQTPSSDPENALEVNGAEVTGEKENHCDDKTCVPSTSAEDMSENVPIAEDTTEQPKKNRITYSQIIKEGRRFNIDLVSKLLYSRGLLIDLLIKSNVSRYAEFKNITRILAFREGRVEQVPCSRADVFNSKQLTMVEKRMLMKFLTFCMEYEKYPDEYKGYEEITFYEYLKTQKLTPNLQYIVMHSIAMTSETASSTIDGLKATKNFLHCLGRYGNTPFLFPLYGQGELPQCFCRMCAVFGGIYCLRHSVQCLVVDKESRKCKAIIDQFGQRIISEHFLVEDSYFPENMCSRVQYRQISRAVLITDRSVLKTDSDQQISILTVPAEEPGTFAVRVIELCSSTMTCMKGTYLVHLTCTSSKTAREDLESVVQKLFVPYTEMEIENEQVEKPRILWALYFNMRDSSDISRSCYNDLPSNVYVCSGPDCGLGNDNAVKQAETLFQEICPNEDFCPPPPNPEDIILDGDSLQPEASESSAIPEANSETFKESTNLGNLEESSE
Species
Homo sapiens (Human)
Preparation and Storage
Store at -20 degree C, for extended storage, conserve at -20 degree C or -80 degree C.
Related Product Information for CHM recombinant protein
Substrate-binding subunit of the Rab geranylgeranyltransferase (GGTase) complex. Binds unprenylated Rab proteins and presents the substrate peptide to the catalytic component B composed of RABGGTA and RABGGTB, and remains bound to it after the geranylgeranyl transfer reaction. The component A is thought to be regenerated by transferring its prenylated Rab back to the donor membrane. Besides, a pre-formed complex consisting of CHM and the Rab GGTase dimer (RGGT or component B) can bind to and prenylate Rab proteins; this alternative pathway is proposed to be the predominant pathway for Rab protein geranylgeranylation.
Product Categories/Family for CHM recombinant protein
References
"Cloning and characterization of the human choroideremia gene." van Bokhoven H., van den Hurk J.A., Bogerd L., Philippe C., Gilgenkrantz S., de Jong P., Ropers H.-H., Cremers F.P. Hum. Mol. Genet. 3:1041-1046(1994)
NCBI and Uniprot Product Information
NCBI GI #
NCBI GeneID
NCBI Accession #
NCBI GenBank Nucleotide #
Molecular Weight
77.5 kDa
NCBI Official Full Name
rab proteins geranylgeranyltransferase component A 1 isoform a
NCBI Official Synonym Full Names
choroideremia (Rab escort protein 1)
NCBI Official Symbol
CHM
NCBI Official Synonym Symbols
TCD; GGTA; REP-1; DXS540; HSD-32
NCBI Protein Information
rab proteins geranylgeranyltransferase component A 1
UniProt Protein Name
Rab proteins geranylgeranyltransferase component A 1
UniProt Gene Name
CHM
UniProt Synonym Gene Names
REP1; TCD; REP-1
UniProt Entry Name
RAE1_HUMAN
Customer Reviews
Loading reviews...
Share Your Experience
Similar Products
Product Notes
The CHM chm (Catalog #AAA113679) is a Recombinant Protein produced from E Coli or Yeast or Baculovirus or Mammalian Cell and is intended for research purposes only. The product is available for immediate purchase. The immunogen sequence is 1-653aa; Full Length Protein of Isoform 1. The amino acid sequence is listed below: MADTLPSEFD VIVIGTGLPE SIIAAACSRS GRRVLHVDSR SYYGGNWASF SFSGLLSWLK EYQENSDIVS DSPVWQDQIL ENEEAIALSR KDKTIQHVEV FCYASQDLHE DVEEAGALQK NHALVTSANS TEAADSAFLP TEDESLSTMS CEMLTEQTPS SDPENALEVN GAEVTGEKEN HCDDKTCVPS TSAEDMSENV PIAEDTTEQP KKNRITYSQI IKEGRRFNID LVSKLLYSRG LLIDLLIKSN VSRYAEFKNI TRILAFREGR VEQVPCSRAD VFNSKQLTMV EKRMLMKFLT FCMEYEKYPD EYKGYEEITF YEYLKTQKLT PNLQYIVMHS IAMTSETASS TIDGLKATKN FLHCLGRYGN TPFLFPLYGQ GELPQCFCRM CAVFGGIYCL RHSVQCLVVD KESRKCKAII DQFGQRIISE HFLVEDSYFP ENMCSRVQYR QISRAVLITD RSVLKTDSDQ QISILTVPAE EPGTFAVRVI ELCSSTMTCM KGTYLVHLTC TSSKTAREDL ESVVQKLFVP YTEMEIENEQ VEKPRILWAL YFNMRDSSDI SRSCYNDLPS NVYVCSGPDC GLGNDNAVKQ AETLFQEICP NEDFCPPPPN PEDIILDGDS LQPEASESSA IPEANSETFK ESTNLGNLEE SSE. It is sometimes possible for the material contained within the vial of "Rab proteins geranylgeranyltransferase component A 1, Recombinant Protein" to become dispersed throughout the inside of the vial, particularly around the seal of said vial, during shipment and storage. We always suggest centrifuging these vials to consolidate all of the liquid away from the lid and to the bottom of the vial prior to opening. Please be advised that certain products may require dry ice for shipping and that, if this is the case, an additional dry ice fee may also be required.Precautions
All products in the AAA Biotech catalog are strictly for research-use only, and are absolutely not suitable for use in any sort of medical, therapeutic, prophylactic, in-vivo, or diagnostic capacity. By purchasing a product from AAA Biotech, you are explicitly certifying that said products will be properly tested and used in line with industry standard. AAA Biotech and its authorized distribution partners reserve the right to refuse to fulfill any order if we have any indication that a purchaser may be intending to use a product outside of our accepted criteria.Disclaimer
Though we do strive to guarantee the information represented in this datasheet, AAA Biotech cannot be held responsible for any oversights or imprecisions. AAA Biotech reserves the right to adjust any aspect of this datasheet at any time and without notice. It is the responsibility of the customer to inform AAA Biotech of any product performance issues observed or experienced within 30 days of receipt of said product. To see additional details on this or any of our other policies, please see our Terms & Conditions page.Item has been added to Shopping Cart
If you are ready to order, navigate to Shopping Cart and get ready to checkout.